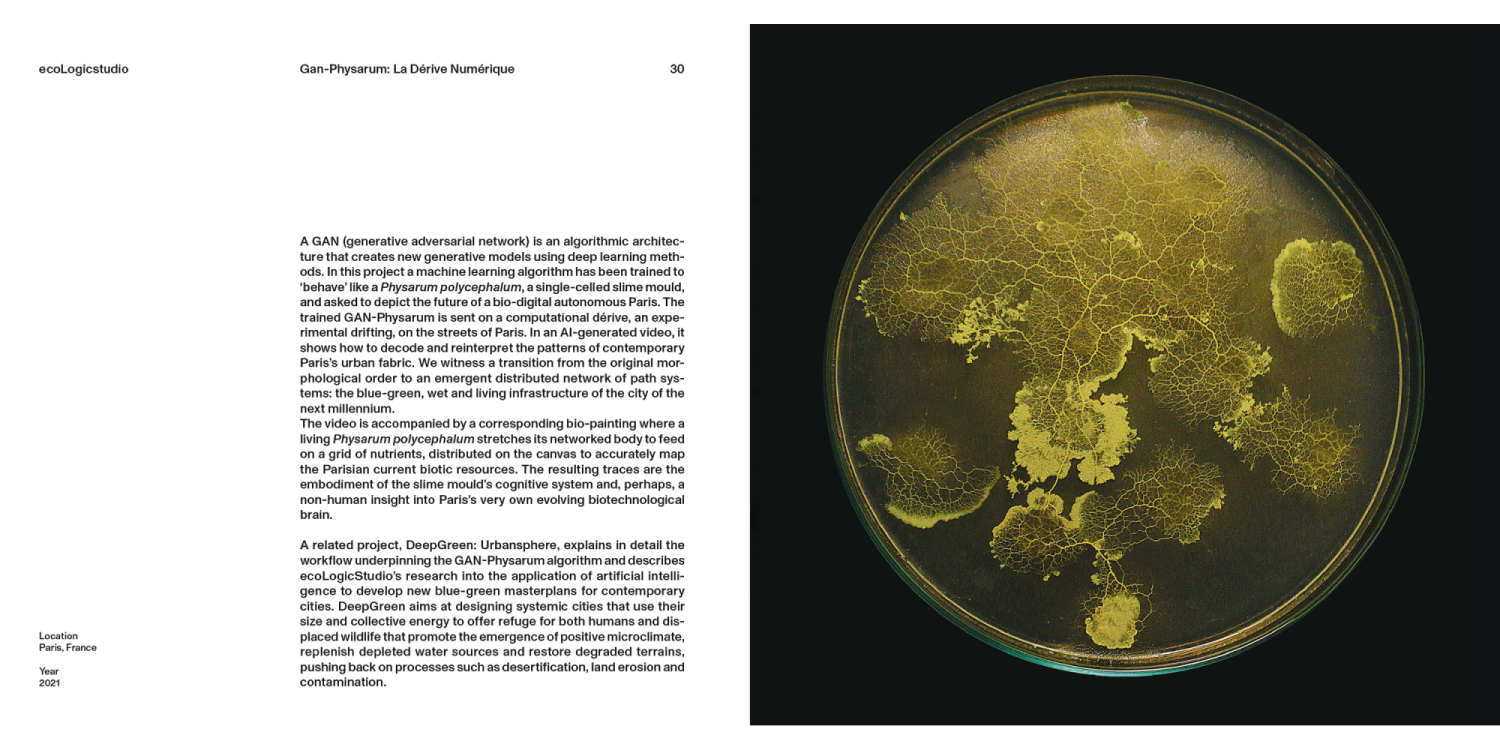
Architecture Connecting 04

Architecture Connecting
“Architecture Connecting: Living Structures” is the first book accompanying a new exhibition series at the Louisiana Museum of Modern Art and presents three design studios with a diverse use of biology and biochemistry as a basis for their practices: ecoLogicStudio, Atelier LUMA and Jenny Sabin Studio. Conscious of our connection to all living things and tracking technological advances, not least in artificial intelligence tools, the studios are developing new methods to review issues of sustainable architecture and climate concerns. This book unfolds their practices, highlighting some of their most important projects. The richly illustrated catalog also comprises a conversation between each design studio and an expert in the field of architecture: Jan Boelen from Atelier LUMA in conversation with Hashim Sarkis, Jenny Sabin in conversation with Mette Ramsgaard, and ecoLogicStudio in conversation with Mario Carpo.
ecoLogicStudio, founded by Marco Poletto and Claudia Pasquero, is a design studio in London working with biodigital architecture. With a focus on climate and carbon neutrality, they research how photosynthesis can be incorporated into architecture.
ATELIER LUMA is the research design lab of LUMA Arles, France, working with bioregional design and architecture. They have built their own studio by mapping and identifying the local resources of the unique bioregion of Camargue.
JENNY SABIN is an architect and researcher working at the crossroads between architecture and science. Theory and knowledge from biology and mathematics help to develop new digital tools, materials and architectural structures that work in interaction with people and nature.
“Architecture Connecting: Living Structures” is the first book accompanying a new exhibition series at the Louisiana Museum of Modern Art and presents three design studios with a diverse use of biology and biochemistry as a basis for their practices: ecoLogicStudio, Atelier LUMA and Jenny Sabin Studio. Conscious of our connection to all living things and tracking technological advances, not least in artificial intelligence tools, the studios are developing new methods to review issues of sustainable architecture and climate concerns. This book unfolds their practices, highlighting some of their most important projects. The richly illustrated catalog also comprises a conversation between each design studio and an expert in the field of architecture: Jan Boelen from Atelier LUMA in conversation with Hashim Sarkis, Jenny Sabin in conversation with Mette Ramsgaard, and ecoLogicStudio in conversation with Mario Carpo.
ecoLogicStudio, founded by Marco Poletto and Claudia Pasquero, is a design studio in London working with biodigital architecture. With a focus on climate and carbon neutrality, they research how photosynthesis can be incorporated into architecture.
ATELIER LUMA is the research design lab of LUMA Arles, France, working with bioregional design and architecture. They have built their own studio by mapping and identifying the local resources of the unique bioregion of Camargue.
JENNY SABIN is an architect and researcher working at the crossroads between architecture and science. Theory and knowledge from biology and mathematics help to develop new digital tools, materials and architectural structures that work in interaction with people and nature.